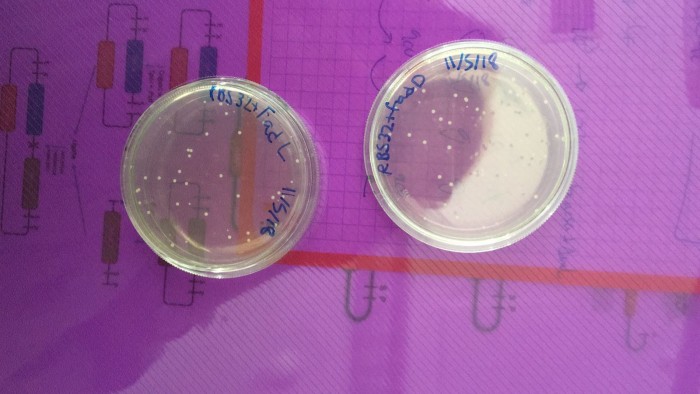
Primers resultats satisfactoris!!

Contributing £ 2
Appreciation
We thank you for the donation.
> 00 Co-financiers
Goteo ha construido una historia única en el mundo del micromecenazgo. ¿Quieres seguir formando parte de ella?
Biologia sintètica contra la metàstasi


 Min.
Min.
 Opt.
Opt.
We thank you for the donation.
In appreciation for the donation, we will post a thank-you note in our webpage.
In appreciation for the donation, we will post a thank-you note in our webpage and twitter.
Personalised sticker and a note of gratitude in our social networks and webpage.
Personalised sticker and a t-shirt and a note of gratitude in our social networks and webpage.
Personalised poster, sticker and a t-shirt, and a note of gratitude in our social networks and webpage.
Guided tour in our laboratory. In addition, personalised poster, sticker and a t-shirt, and a note of gratitude in our social networks and webpage.
Special mention of gratitude in our social networks and webpage. In addition: personalised poster, sticker and a t-shirt.
Appearance in our posters and our events. Special mention of gratitude in our social networks and webpage. In addition: personalised poster, sticker and a t-shirt.
Image of our team. Appearance in our posters and our events, present and future. Special mention of gratitude in our social networks and webpage. In addition: personalised poster, sticker and a t-shirt.
Per tots aquells que ens heu ajudat,
Tenim molt bones notícies! Ja fa unes setmanes que hem començat la part experimental del nostre projecte i us volem anunciar que tenim bons resultats! Treballant fort hem aconseguit que els bacteris amb els quals estem treballant expressin el nostre primer constructe. Anem avançant per, en mica en mica, anar aconseguint el nostre objectiu.
I recordeu, només queden 3 dies per acabar la campanya! Tota ajuda ens vindrà bé.
Us tornem a donar les gràcies a tots aquells que ens heu ajudat,
Equip de l'iGEM.
Inicia sesión para dejar un comentario
Appreciation
We thank you for the donation.
> 00 Co-financiers
Appreciation + mention
In appreciation for the donation, we will post a thank-you note in our webpage.
> 21 Co-financiers
Appreciation + mention
In appreciation for the donation, we will post a thank-you note in our webpage and twitter.
> 12 Co-financiers
Sticker + Appreciation
Personalised sticker and a note of gratitude in our social networks and webpage.
> 22 Co-financiers
T-Shirt + Sticker
Personalised sticker and a t-shirt and a note of gratitude in our social networks and webpage.
> 18 Co-financiers
Poster + T-shirt + sticker
Personalised poster, sticker and a t-shirt, and a note of gratitude in our social networks and webpage.
> 08 Co-financiers
Guided tour in our laboratory + all of above
Guided tour in our laboratory. In addition, personalised poster, sticker and a t-shirt, and a note of gratitude in our social networks and webpage.
> 01 Co-financiers
Bronze sponsorship
Special mention of gratitude in our social networks and webpage. In addition: personalised poster, sticker and a t-shirt.
> 00 Co-financiers
Silver sponsorship
Appearance in our posters and our events. Special mention of gratitude in our social networks and webpage. In addition: personalised poster, sticker and a t-shirt.
> 01 Co-financiers
Gold sponsorship
Image of our team. Appearance in our posters and our events, present and future. Special mention of gratitude in our social networks and webpage. In addition: personalised poster, sticker and a t-shirt.
> 00 Co-financiers